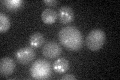
YIL158W
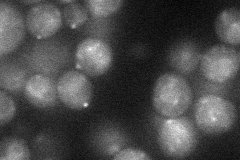
YIL158W
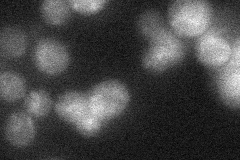
YIL158W
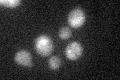
YIL158W
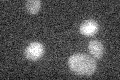
YIL158W

View description
Putative protein of unknown function; overexpression causes a cell cycle delay or arrest; green fluorescent protein (GFP)-fusion protein localizes to the vacuole; null mutant displays elevated frequency of mitochondrial genome loss
Localization:
Intensity:
Fold change:
Significance:
-
C’ GFP library in SD
vacuole22.75 -
N' NOP1pr-GFP in SD
punctate33.8602 -
N' TEF2pr-mCherry in SD

punctate14.5934 -
N' NATIVEpr-GFP in SD
ambiguous24.1003 -
N' TEF2pr-VC and Cyto-VN in SD

below threshold24.1053 -
C’ GFP library in SD+DTT
vacuole17.80.78Yes -
C’ GFP library in SD+H2O2

vacuole15.480.68Yes -
C’ GFP library in Starvation Media
vacuole150.65Yes -
C’ GFP library on the background of Pup2-DaMP

vacuole -
C’ GFP library on the background of CCT mutant

vacuole22.10530.971329No
